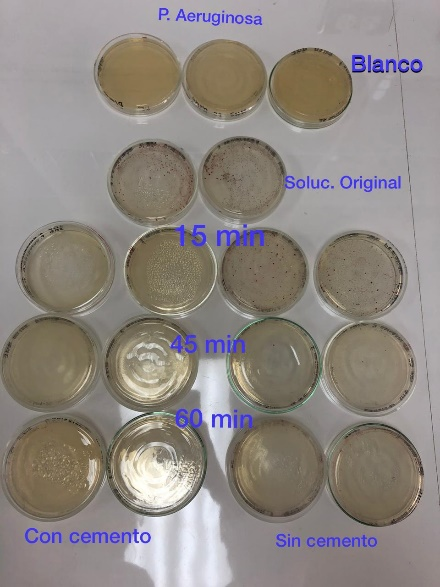

Laboratorio de Grafeno
Se especializa en materiales bidimensionales o la superficie de materiales macro. Especialmente en materiales derivados del grafito.
Biosensores
Específicamente con el grafeno se ha trabajado en biosensores para la detección de patógenos como el C. difficile en colaboración con el CIET de la escuela de Microbiología y el LANOBIOS del CICANUM. Estos dispositivos detectan el patógeno tanto por efecto de campo como por fluorescencia, son de los dispositivos llamados “lab on a chip”. Aparte de la versatilidad en las propiedades físicas que presentan estos dispositivos para la detección, también cuentan con microcanales que permiten realizar dielectroforesis para concentrar el patógeno.



Baterías
En colaboración con el LabVolta del CELEQ también se han utilizado superficies de grafito o grafito modificadas con nano-partículas de sílica, óxido de estaño, entre otros y materiales moleculares como ferroceno como electrodos en batería de Ion Aluminio. Dichos materiales presentan resultados promisorios.

TiOx
Se ha estudiado el dopaje de cemento con óxido de titanio nanoparticulado para la generación de un cemento fotocatalíco. Este cemento no solo presenta las propiedades de auto lavado, sino que también permite la eliminación de diferentes patógenos en el agua cuando es expuesta a rayos Ultra violeta